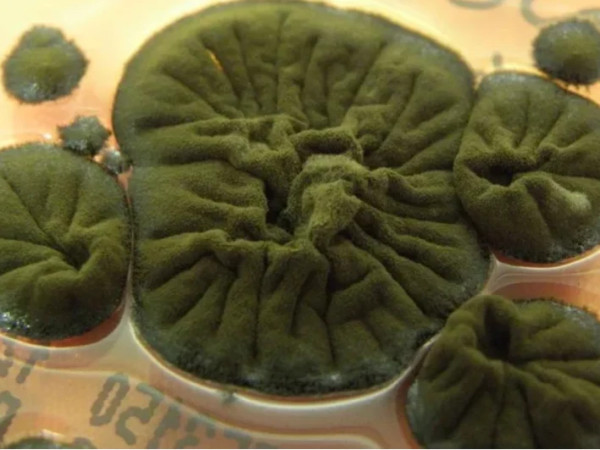

დღის სიახლეები
პოლიტიკა
საზოგადოება
„მოთმინებით ველოდებით აშშ-ის პოზიციას საქართველოსთან მიმართებით“ - ირაკლი კობახიძე
კანონისა და წესრიგის ინდექსის მიხედვით, საქართველო სახელმწიფოებს შორის მსოფლიოში მე-19 ადგილზეა და ევროკავშირის წევრ მხოლოდ 4 ქვეყანას ჩამორჩება
სენატის უმრავლესობის ლიდერმა, ჯონ ტუნიმ უარი თქვა სპიკერ მაიკ ჯონსონის თხოვნაზე, „მეგობარი აქტი“ ეროვნული თავდაცვის ავტორიზაციის აქტს დამატებოდა- The Hill
ჩვენ მზად ვიქნებით ევროკავშირში ინტეგრაციისთვის 2030 წლისთვის, დანარჩენი დამოკიდებულია სამართლიანობაზე - ირაკლი კობახიძე
რუსეთსა და საქართველოს შორის პოლიტიკური დიალოგის განახლებისთვის არანაირი წინაპირობა არ არსებობს - რუსეთის საგარეო უწყება
„მოთმინებით ველოდებით აშშ-ის პოზიციას საქართველოსთან მიმართებით“ - ირაკლი კობახიძე
კანონისა და წესრიგის ინდექსის მიხედვით, საქართველო სახელმწიფოებს შორის მსოფლიოში მე-19 ადგილზეა და ევროკავშირის წევრ მხოლოდ 4 ქვეყანას ჩამორჩება
სენატის უმრავლესობის ლიდერმა, ჯონ ტუნიმ უარი თქვა სპიკერ მაიკ ჯონსონის თხოვნაზე, „მეგობარი აქტი“ ეროვნული თავდაცვის ავტორიზაციის აქტს დამატებოდა- The Hill
ჩვენ მზად ვიქნებით ევროკავშირში ინტეგრაციისთვის 2030 წლისთვის, დანარჩენი დამოკიდებულია სამართლიანობაზე - ირაკლი კობახიძე
რუსეთსა და საქართველოს შორის პოლიტიკური დიალოგის განახლებისთვის არანაირი წინაპირობა არ არსებობს - რუსეთის საგარეო უწყება